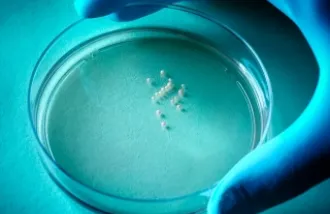
3D brain cultures

Displaying 1001 - 1020 news posts of 1425
At Stanford, tiny answers to biology’s biggest questions
As Stanford interdisciplinary scientists find new ways to push, pull and sometimes simply jiggle cells and even individual molecules, they’re also discovering microscopic answers to some of the biggest questions in biology and health.
Neuron Q&A with Robert Malenka
In an interview with Neuron, Robert Malenka shares his favorite discovery moments and discusses his philosophy for running a lab, the influence of his clinical training, and his broad interests, ranging from basic synaptic physiology to circuits mediating
Stanford researchers listen for silent seizures with "brain stethoscope" that turns brain waves into sound
By converting brain waves into sound, even non-specialists can detect “silent seizures” – epileptic seizures without the convulsions most of us expect.
Advances offer new hope for stroke survivors
Researchers like Marion Buckwalter and her colleague Maarten Lansberg, MD, PhD, an associate professor of neurology and neurological sciences, are working on how to prevent dementia in stroke survivors, nearly half of whom develop the condition in the fir
“Brain balls” let scientists mimic, study neurodevelopmental disorders in a dish
The human brain is one of the great mysteries in science, and it's a tough nut to crack. How can you study its development when so much of it takes place while a child is still in its mother's uterus?
Politeness can sometimes hurt more than it helps
our culture is in the middle of a politeness shortage. Imagine a reader from five years ago leafing through today’s Washington Post. She’d probably be shocked at the vulgarity of our national conversation. Social media is overrun with bullying.
Advanced cell-labeling technology identifies suspect cell type, possible new therapeutic approach to multiple sclerosis
There's no known cure for multiple sclerosis. But Stanford neuroimmunologist Larry Steinman, MD, has been working on it for decades.
Kids see words and faces differently
It probably comes as no surprise that kids see the world differently from adults, or that the difference in viewpoint extends to how they see things like words. What may come as a surprise is that to most easily process the words they see, they need to lo
Neuroscience awards named in honor of Ben Barres
The Chan Zuckerberg Initiative (CZI), a Palo Alto-based philanthropic organization, has launched a major research effort to inject fresh energy, ideas and talent into understanding the basic biology of neurodegenerative conditions such as Alzheimer’s dise
Stanford researchers find that kids see words and faces differently from adults
A new study finds that young children’s brains have not yet fully developed the vision circuits they need to understand words and recognize faces, a finding that could help in understanding how children learn to read.
Mental rehearsal prepares our minds for real-world action
Mentally running through a routine improves performance, but how that works isn’t clear. Now, a new tool — brain-machine interface — suggests the answer lies in how our brains prepare for action.
Healthy minds with Dr. Jeffrey Borenstein - Obsessive-Compulsive Disorder
New research will transform the treatment of obsessive-compulsive disorder (OCD). Carolyn Rodriguez, M.D., Ph.D. Director of the Translational OCD Research Program at Stanford Medicine, explains the latest research including potential rapid acting medicat
Neuroscience awards in honor of Ben Barres introduced by Chan Zuckerberg Initiative
A new, early career award in neuroscience was created by the Chan Zuckerberg Initiative in honor of the late Stanford neuroscientist Ben Barres.
Defects in mitochondria, cells’ internal power packs, further linked to Parkinson’s in Stanford study
New research suggests that targeting mitochondria could be a way to treat Parkinson's disease.
Neuroscience awards named in honor of Ben Barres
The five-year awards from the Chan Zuckerberg Initiative will help fuel research into the biology of neurodegenerative diseases. The awards honor a Stanford neuroscientist who died in December.
Defects in mitochondria, cells’ internal power packs, further linked to Parkinson’s in Stanford study
Defective architecture in the nanoscopic power plants that provide energy to every cell in our bodies may underlie the movement difficulties of Parkinson's disease, a new study by Stanford neuroscientist Xinnan Wang, MD, and her associates suggests.
Stanford researchers show how mental rehearsal prepares our minds for action
Mentally running through a routine improves performance. A new tool – brain-machine interface – sheds light on how.
Exercise elevates blood signature difference between people with, without chronic fatigue syndrome
A bout of exercise is about the last thing you'd imagine a person with chronic fatigue syndrome – also known as myalgic encephalomyelitis and often designated by the acronym ME/CFS – would want to endure. And you'd probably be right.